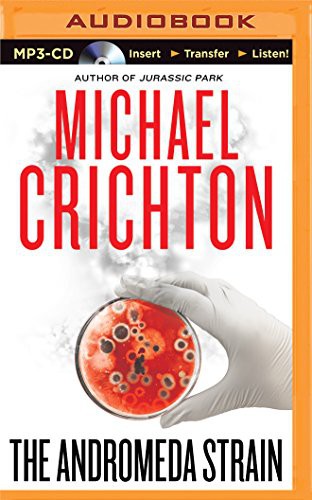
Michael Crichton, David Morse: Andromeda Strain, The (AudiobookFormat, Brilliance Audio)

Editions of The Andromeda Strain
Filters
The Andromeda strain
294 pages
English language
Published 1988 by Pan, Pan Books.
- OCLC Number:
- 220908776
The Andromeda Strain
audio cd
English language
Published by RH Audio Price-less.
- ISBN:
- 978-0-7393-1225-4
Andromeda
255 pages
Undetermined language
Published 1981 by Droemer Knaur.
- ISBN:
- 978-3-426-05731-5
- OCLC Number:
- 645676704
The Andromeda Strain
mass market paperback, 294 pages
Published July 1971 by Dell.
- OCLC Number:
- 475525231
The Andromeda Strain
Hardcover, 608 pages
English language
Published by Ulverscroft Large Print.
- ISBN:
- 978-0-7089-8937-1
- OCLC Number:
- 59651908
O Enigma de Andromeda (Em Portugues do Brasil)
Paperback
Published by ALEPH.
- ISBN:
- 978-85-7657-374-6
The Andromeda Strain
mass market paperback
English language
Published June 1970 by Dell.
- OCLC Number:
- 912868172
Can't find the edition you're looking for?